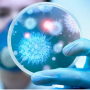

Գյումրին ապացուցեց, որ ընտրություններով կարելի է իշխանություն փոխել. Ավետիք Չալաբյան
Քաղաքականություն

 Հայտնի է Գյումրի-Մոսկվա չվերթի ինքնաթիռի հարկադիր վայրէջքի պատճառը
Հայտնի է Գյումրի-Մոսկվա չվերթի ինքնաթիռի հարկադիր վայրէջքի պատճառը
 Սպասվում է առանց տեղումների եղանակ. առանձին շրջաններում հնարավոր է կարճատև անձրև և ամպրոպ
Սպասվում է առանց տեղումների եղանակ. առանձին շրջաններում հնարավոր է կարճատև անձրև և ամպրոպ
 Քիչ առաջ ջրասուզակներն և փրկարարները Փամբակ գետում հայտնաբերել են 13-ամյա աղջկա մարմինը
Քիչ առաջ ջրասուզակներն և փրկարարները Փամբակ գետում հայտնաբերել են 13-ամյա աղջկա մարմինը
 Ադրբեջանն է մեզանից կախվածության մեջ հայտնվում. Սամվել Մարտիրոսյանը՝ Team-ի և Azertelecom-ի համաձայնագրի մասին
Ադրբեջանն է մեզանից կախվածության մեջ հայտնվում. Սամվել Մարտիրոսյանը՝ Team-ի և Azertelecom-ի համաձայնագրի մասին
 Այսօր կկայանա Յունիբանկի բաժնետերերի տարեկան ընդհանուր ժողովը. բանկի զուտ շահույթը կազմել է 9.8 մլրդ դրամ
Այսօր կկայանա Յունիբանկի բաժնետերերի տարեկան ընդհանուր ժողովը. բանկի զուտ շահույթը կազմել է 9.8 մլրդ դրամ
 Հայաստանի կանանց թենիսի հավաքականը պատմական հաջողություն է գրանցել՝ 17 տարվա դադարից հետո վերադառնալով II խումբ
Հայաստանի կանանց թենիսի հավաքականը պատմական հաջողություն է գրանցել՝ 17 տարվա դադարից հետո վերադառնալով II խումբ
 8-րդ օրն է՝ Փամբակ գետում որոնում են 13-ամյա աղջկան
8-րդ օրն է՝ Փամբակ գետում որոնում են 13-ամյա աղջկան 34 միլիոն եվրո՝ ձախողումները քողարկելու համար. ո՞ւր հասցրին հայկական արտահանումը
34 միլիոն եվրո՝ ձախողումները քողարկելու համար. ո՞ւր հասցրին հայկական արտահանումը
 «Տելեկոմ Արմենիա» և «Ազերտելեկոմ» ընկերությունները ստորագրել են ինտերնետ տրաֆիկի տարանցման վերաբերյալ համաձայնագիր
«Տելեկոմ Արմենիա» և «Ազերտելեկոմ» ընկերությունները ստորագրել են ինտերնետ տրաֆիկի տարանցման վերաբերյալ համաձայնագիր
 Ո՞ւր կորավ 1988-ի միասնական և հայրենասեր հայ ժողովուրդը․ Լիլիթ Արզումանյան
Ո՞ւր կորավ 1988-ի միասնական և հայրենասեր հայ ժողովուրդը․ Լիլիթ Արզումանյան Այն մասին, թե ինչպիսի լեգիտիմության ճգնաժամ է առաջացել գործող վարչախմբի համար. Ավետիք Չալաբյան
Այն մասին, թե ինչպիսի լեգիտիմության ճգնաժամ է առաջացել գործող վարչախմբի համար. Ավետիք Չալաբյան Մբապեն նշել է աշխարհի երկու լավագույն ֆուտբոլիստներին
Մբապեն նշել է աշխարհի երկու լավագույն ֆուտբոլիստներին
 Գյումրի-Քարակետ մայրուղու Արտենի գյուղի տարածքում բախվել են մարդատար «Գազելը» ու «Զիլ» բեռնատարը․ կա 1 զnh, 11 տուժած
Գյումրի-Քարակետ մայրուղու Արտենի գյուղի տարածքում բախվել են մարդատար «Գազելը» ու «Զիլ» բեռնատարը․ կա 1 զnh, 11 տուժած
 Իրանին հաջողվել է լուծել մի շարք հարցեր Կատարի և Պակիստանի շնորհիվ. Արաղչի
Իրանին հաջողվել է լուծել մի շարք հարցեր Կատարի և Պակիստանի շնորհիվ. Արաղչի
 Երկրաշարժ՝ Իջևանից 20 կմ հյուսիս-արևմուտք
Երկրաշարժ՝ Իջևանից 20 կմ հյուսիս-արևմուտք
 3 քաղաքացու վիճակը գնահատվում է ծայրահեղ ծանր, 5 քաղաքացու վիճակը՝ ծանր․ ԱՆ-ն՝ Արտենի գյուղի մոտակայքում տեղի ունեցած վթարի մասին
3 քաղաքացու վիճակը գնահատվում է ծայրահեղ ծանր, 5 քաղաքացու վիճակը՝ ծանր․ ԱՆ-ն՝ Արտենի գյուղի մոտակայքում տեղի ունեցած վթարի մասին
 Էլեկտրաէներգիայի անջատումներ Երևանի 7 վարչական շրջաններում և բոլոր 10 մարզերում
Էլեկտրաէներգիայի անջատումներ Երևանի 7 վարչական շրջաններում և բոլոր 10 մարզերում
 Ստորագրահավաք Ազատության հրապարակում հանուն Հայաստանի, միացի՜ր․ ՀՃ
Ստորագրահավաք Ազատության հրապարակում հանուն Հայաստանի, միացի՜ր․ ՀՃ Արզնու խճուղում բшխվել են «Nissan Tiida»-ն ու «Toyota Camry»-ն
Արզնու խճուղում բшխվել են «Nissan Tiida»-ն ու «Toyota Camry»-ն Վաղվանից սկսած աստիճանաբար օդի ջերմաստիճանը կսկսի նվազել․ Գագիկ Սուրենյան
Վաղվանից սկսած աստիճանաբար օդի ջերմաստիճանը կսկսի նվազել․ Գագիկ Սուրենյան Ովքեր դեմ են ընտրության արդյունքներին առաջարկում եմ միանալ Արշակ Կարապետյանի կոչին և Ազատության հրապարակում մասնակցել կազմակերպված ստորագրահավաքին. Արտյոմ Սիմոնյան
Ովքեր դեմ են ընտրության արդյունքներին առաջարկում եմ միանալ Արշակ Կարապետյանի կոչին և Ազատության հրապարակում մասնակցել կազմակերպված ստորագրահավաքին. Արտյոմ Սիմոնյան Հորմուզի նեղուցում hրադադարի ժամանակահատվածում անցման համար վճար չի գանձվելnւ, այն չի գանձվելու նաև այդ 60 օրից հետո, եթե միայն դա չանի ԱՄՆ-ը․ Թրամփ
Հորմուզի նեղուցում hրադադարի ժամանակահատվածում անցման համար վճար չի գանձվելnւ, այն չի գանձվելու նաև այդ 60 օրից հետո, եթե միայն դա չանի ԱՄՆ-ը․ Թրամփ 1 զnh, 6 վիրավnր. Արագածոտնի մարզում բшխվել են «Chevrolet Volt»-ը և «Opel»-ը
1 զnh, 6 վիրավnր. Արագածոտնի մարզում բшխվել են «Chevrolet Volt»-ը և «Opel»-ը Թշնամիներ արտադրող գործարանը. «Ռուսական միջամտության» կեղծ թեզերը՝ որպես քաղաքական հալածանքների գործիք
Թշնամիներ արտադրող գործարանը. «Ռուսական միջամտության» կեղծ թեզերը՝ որպես քաղաքական հալածանքների գործիք Թայվանում բացվել է Զահա Հադիդի նախագծած աշխարհի ամենաերկար ասիմետրիկ կամուրջը
Թայվանում բացվել է Զահա Հադիդի նախագծած աշխարհի ամենաերկար ասիմետրիկ կամուրջը Ընդդիմադիր քաղաքական ուժերը պետք է գործեն համատեղ՝ հանուն Հաայստանի Հանրապետության․ Արմեն Մանվելյան
Ընդդիմադիր քաղաքական ուժերը պետք է գործեն համատեղ՝ հանուն Հաայստանի Հանրապետության․ Արմեն Մանվելյան Ադրբեջանը բացահայտ ներկայացնում է իր նպատակը. վերադարձի փառատոնը և մեր լռությունը․ Էդմոն Մարուքյան
Ադրբեջանը բացահայտ ներկայացնում է իր նպատակը. վերադարձի փառատոնը և մեր լռությունը․ Էդմոն Մարուքյան  Մենք հիանալի հարաբերություններ ունենք Հայաստանի, Ադրբեջանի և Թուրքիայի հետ․ Կոբախիձե
Մենք հիանալի հարաբերություններ ունենք Հայաստանի, Ադրբեջանի և Թուրքիայի հետ․ Կոբախիձե Արի՜ Ազատության հրապարակ․ Համահայկական Ճակատ
Արի՜ Ազատության հրապարակ․ Համահայկական Ճակատ Դավիթ Բեկ փողոցում բшխվել են «Mitsubishi»-ն և «Dodge»-ը
Դավիթ Բեկ փողոցում բшխվել են «Mitsubishi»-ն և «Dodge»-ը
 Թշնամու դավադիր կրակոցը խլեց Լեոնիդ Ազգալդյանի կյանքը, բայց ոչ նրա գաղափարը․ Համահայկական ճակատ
Թշնամու դավադիր կրակոցը խլեց Լեոնիդ Ազգալդյանի կյանքը, բայց ոչ նրա գաղափարը․ Համահայկական ճակատ Հորոսկոպ. ձեր նշանի տեսողական գեղագիտությունը
Հորոսկոպ. ձեր նշանի տեսողական գեղագիտությունը
 Ադրբեջանից Հայաստան կուղարկվի 17 վագոն դիզելային վառելիք
Ադրբեջանից Հայաստան կուղարկվի 17 վագոն դիզելային վառելիք
 Կոտայքի մարզում «Volkswagen ID. UNYX»-ը բшխվել է կայանված «Lada Priora»-ին և «Mercedes»-ին. վերջինը առաջ է ընթացել և բшխվել «Renault»-ին
Կոտայքի մարզում «Volkswagen ID. UNYX»-ը բшխվել է կայանված «Lada Priora»-ին և «Mercedes»-ին. վերջինը առաջ է ընթացել և բшխվել «Renault»-ին «Ռեալը» հետաքրքրված է Մարոկկոյի ազգային հավաքականի կիսապաշտպան Այուբ Բուադիի ծառայություններով
«Ռեալը» հետաքրքրված է Մարոկկոյի ազգային հավաքականի կիսապաշտպան Այուբ Բուադիի ծառայություններով Իրանը փակում է Հորմուզի նեղուցը՝ ի պատասխան Իսրայելի կողմից Լիբանանի դեմ շարունակվող ագրեuիայի․ Իրանի ԶՈւ կենտրոնական շտաբ
Իրանը փակում է Հորմուզի նեղուցը՝ ի պատասխան Իսրայելի կողմից Լիբանանի դեմ շարունակվող ագրեuիայի․ Իրանի ԶՈւ կենտրոնական շտաբ Meta ընկերությունը պայմանագիր է կնքել տիեզերքից «գիշերային» արևային էներգիա ստանալու համար արհեստական բանականության տվյալների կենտրոնների համար
Meta ընկերությունը պայմանագիր է կնքել տիեզերքից «գիշերային» արևային էներգիա ստանալու համար արհեստական բանականության տվյալների կենտրոնների համար Մյունխենում բեռնատար գնացքի երկու վագոն է կախվել կամրջից և ընկել փողոցի վրա. 1 մարդ է զոհվել
Մյունխենում բեռնատար գնացքի երկու վագոն է կախվել կամրջից և ընկել փողոցի վրա. 1 մարդ է զոհվել Խուսափե՛ք արևի ճառաջայթներից 11:00-17:00-ն ընկած ժամանակահատվածում․ ՀՎԿ ազգային կենտրոն
Խուսափե՛ք արևի ճառաջայթներից 11:00-17:00-ն ընկած ժամանակահատվածում․ ՀՎԿ ազգային կենտրոն Այսօր ես խոսելու եմ մի ճշմարտության մասին, որը տարիներ շարունակ փորձել են լռեցնել, ծաղրել կամ քողարկել գեղեցիկ, բայց փուչ լիբերալ լոզունգների տակ․ Հրայր Կամենադատյան
Այսօր ես խոսելու եմ մի ճշմարտության մասին, որը տարիներ շարունակ փորձել են լռեցնել, ծաղրել կամ քողարկել գեղեցիկ, բայց փուչ լիբերալ լոզունգների տակ․ Հրայր Կամենադատյան Լոս Անջելեսում բացվել է աշխարհի առաջին արհեստական ինտելեկտի արվեստի թանգարանը
Լոս Անջելեսում բացվել է աշխարհի առաջին արհեստական ինտելեկտի արվեստի թանգարանը Կրասնոդարում երկու երիտասարդ մաչետեներով ու դանակներով հարձակվել են առևտրի կենտրոնի այցելուների վրա. կա զոհ և տուժածներ
Կրասնոդարում երկու երիտասարդ մաչետեներով ու դանակներով հարձակվել են առևտրի կենտրոնի այցելուների վրա. կա զոհ և տուժածներ «Միշտ մտածել եմ՝ ինքդ քեզ հավատարիմ մնալը համարձակությո՞ւն է, թե՞ շքեղություն». Շուշաննա Թովմասյան
«Միշտ մտածել եմ՝ ինքդ քեզ հավատարիմ մնալը համարձակությո՞ւն է, թե՞ շքեղություն». Շուշաննա Թովմասյան Ռոնալդինյոն վերսկսում է կարիերան. բրազիլացին համաձայնության է եկել իտալական ակումբի հետ
Ռոնալդինյոն վերսկսում է կարիերան. բրազիլացին համաձայնության է եկել իտալական ակումբի հետ Պրեմիերա․ Արամե - «Ու թե մի օր»
Պրեմիերա․ Արամե - «Ու թե մի օր»
 Այսօր աշխարհն ապրում է կլիմայի գլոբալ փոփոխություններ, և մենք նույնպես այդ փոփոխությունները և անոմալիաները տեսնում ենք․ Նիկոլ Փաշինյան
Այսօր աշխարհն ապրում է կլիմայի գլոբալ փոփոխություններ, և մենք նույնպես այդ փոփոխությունները և անոմալիաները տեսնում ենք․ Նիկոլ Փաշինյան Խորթ մոր կողմից 1 տարեկան երեխային uպանելnւ դեպքի առթիվ նախաձեռնված քրեական վարույթի նախաքննությունն ավարտվել է
Խորթ մոր կողմից 1 տարեկան երեխային uպանելnւ դեպքի առթիվ նախաձեռնված քրեական վարույթի նախաքննությունն ավարտվել է Ոսկեվանում կարկուտ է տեղում. ՏԵՍԱՆՅՈՒԹ
Ոսկեվանում կարկուտ է տեղում. ՏԵՍԱՆՅՈՒԹ Երևանի Սիսվան փողոցում հնչել են կրшկոցներ
Երևանի Սիսվան փողոցում հնչել են կրшկոցներ Թրամփը հայտարարել է Թուրքիա և Չինաստան այցելելու ծրագրերի մասին
Թրամփը հայտարարել է Թուրքիա և Չինաստան այցելելու ծրագրերի մասին
 1
Ոսկեվանում կարկուտ է տեղում. ՏԵՍԱՆՅՈՒԹ
1
Ոսկեվանում կարկուտ է տեղում. ՏԵՍԱՆՅՈՒԹ
 2
Մահապատժի՛ ենթարկել Հայաստանի անկախությունն ու ինքնիշխանությունը վաճառողներին. Խաչիկ Ասրյան
2
Մահապատժի՛ ենթարկել Հայաստանի անկախությունն ու ինքնիշխանությունը վաճառողներին. Խաչիկ Ասրյան
 3
ԿԸՀ-ն ջնջում է ընտրության իրավունքը. մանդատագողություն բացահայտ ցինիզմով. «Փաստ»
3
ԿԸՀ-ն ջնջում է ընտրության իրավունքը. մանդատագողություն բացահայտ ցինիզմով. «Փաստ»
 4
Ստորագրահավաք Ազատության հրապարակում հանուն Հայաստանի, միացի՜ր․ ՀՃ
4
Ստորագրահավաք Ազատության հրապարակում հանուն Հայաստանի, միացի՜ր․ ՀՃ
 5
«Մի՛ հավատացեք ձեր աչքերին»․ IDBank-ը զգուշացնում է դիփֆեյքերի միջոցով զեղծարարությունների մասին
5
«Մի՛ հավատացեք ձեր աչքերին»․ IDBank-ը զգուշացնում է դիփֆեյքերի միջոցով զեղծարարությունների մասին
 1
Ռուսաստանը չի հանդուրժի Հայաստանի միակողմանի շահ ստանալուն միտված դիրքորոշումը ԵԱՏՄ-ի նկատմամբ. Զախարովա
1
Ռուսաստանը չի հանդուրժի Հայաստանի միակողմանի շահ ստանալուն միտված դիրքորոշումը ԵԱՏՄ-ի նկատմամբ. Զախարովա
 2
«Իմ սիրտն ազատ չէ». Դիմա Բիլանը խոսել է անձնական կյանքից
2
«Իմ սիրտն ազատ չէ». Դիմա Բիլանը խոսել է անձնական կյանքից
 3
Ոսկեվանում կարկուտ է տեղում. ՏԵՍԱՆՅՈՒԹ
3
Ոսկեվանում կարկուտ է տեղում. ՏԵՍԱՆՅՈՒԹ
 4
Ես զգուշացնում եմ, որ դատական հայցեր են ներկայացվելու բոլոր նրանց դեմ, ովքեր կփորձեն խաղալ մեր բարի համբավի հետ. Իվետա Տոնոյան
4
Ես զգուշացնում եմ, որ դատական հայցեր են ներկայացվելու բոլոր նրանց դեմ, ովքեր կփորձեն խաղալ մեր բարի համբավի հետ. Իվետա Տոնոյան
 5
Զինվորների քվեարկության ժամանակ խախտումները արձանագրած լրագրողին անմիջապես կանչել են վարժական հավաքի
5
Զինվորների քվեարկության ժամանակ խախտումները արձանագրած լրագրողին անմիջապես կանչել են վարժական հավաքի
 1
Ռուսաստանը չի հանդուրժի Հայաստանի միակողմանի շահ ստանալուն միտված դիրքորոշումը ԵԱՏՄ-ի նկատմամբ. Զախարովա
1
Ռուսաստանը չի հանդուրժի Հայաստանի միակողմանի շահ ստանալուն միտված դիրքորոշումը ԵԱՏՄ-ի նկատմամբ. Զախարովա
 2
Մենք 15 համարն ենք, հիշեք Մեծ Հայքում ևս 15 նահանգ էր. Արշակ Կարապետյան
2
Մենք 15 համարն ենք, հիշեք Մեծ Հայքում ևս 15 նահանգ էր. Արշակ Կարապետյան
 3
«Իմ սիրտն ազատ չէ». Դիմա Բիլանը խոսել է անձնական կյանքից
3
«Իմ սիրտն ազատ չէ». Դիմա Բիլանը խոսել է անձնական կյանքից
 4
Ոսկեվանում կարկուտ է տեղում. ՏԵՍԱՆՅՈՒԹ
4
Ոսկեվանում կարկուտ է տեղում. ՏԵՍԱՆՅՈՒԹ
5
Ես զգուշացնում եմ, որ դատական հայցեր են ներկայացվելու բոլոր նրանց դեմ, ովքեր կփորձեն խաղալ մեր բարի համբավի հետ. Իվետա Տոնոյան
5
Ես զգուշացնում եմ, որ դատական հայցեր են ներկայացվելու բոլոր նրանց դեմ, ովքեր կփորձեն խաղալ մեր բարի համբավի հետ. Իվետա Տոնոյան
